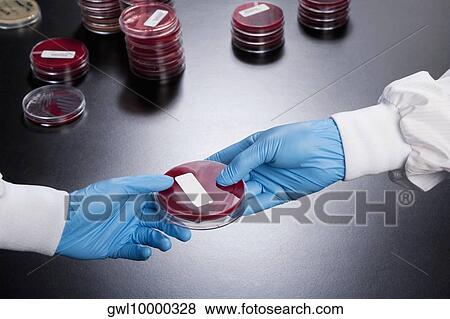

Fotosearch Royalty Free Stock Photography
Digital images licensed by Publitek, Inc.
Fotosearch and Photosearch are trademarks of Fotosearch, LLC
All rights reserved © 2026-01-22
Petri dish in two doctors' hands Stock Photo
Petri dish in two doctors' hands
gwl10000328 | Glow Images RM | Rights Managed
Add to Lightbox
Share Image
Keywords
bacterium, bio technology, biologist, biology, chemistry, close up, close-up, closeup, color image, colour image, container, detection, disclosure, discover, discovered, discovery, dish, doc, doctor, doctor of medicine, doctors, equipment, experiment, expert, expertise, general practitioner, glove, gp, hand, health care, health care provider, health professional, healthcare, healthcare and medicine, healthcare professional, healthcare worker, hold, holding, horizontal, hospital, human hand, indoors, lab, lab technician, label, laboratory, laboratory equipment, md, medical, medical center, medical equipment, medical man, medical occupation, medical practitioner, medical sample, medical science, medicine, occupation, part of, petri dish, photography, physician, profession, professional, professional occupation, protective glove, protective workwear, research, researcher, researching, sample, science, science and technology, scientific, scientific experiment, scientist, scrutiny, skill, skilled, surgeon, two people, uncovering, work, working, stock image, images, royalty free photo, stock photos, stock photograph, stock photographs, picture, pictures, graphic, graphics, fine art prints, print, poster, posters, mural, wall murals, gwl10000328
bacterium, bio technology, biologist, biology, chemistry, close up, close-up, closeup, color image, colour image, container, detection, disclosure, discover, discovered, discovery, dish, doc, doctor, doctor of medicine, doctors, equipment, experiment, expert, expertise, general practitioner, glove, gp, hand, health care, health care provider, health professional, healthcare, healthcare and medicine, healthcare professional, healthcare worker, hold, holding, horizontal, hospital, human hand, indoors, lab, lab technician, label, laboratory, laboratory equipment, md, medical, medical center, medical equipment, medical man, medical occupation, medical practitioner, medical sample, medical science, medicine, occupation, part of, petri dish, photography, physician, profession, professional, professional occupation, protective glove, protective workwear, research, researcher, researching, sample, science, science and technology, scientific, scientific experiment, scientist, scrutiny, skill, skilled, surgeon, two people, uncovering, work, working, stock image, images, royalty free photo, stock photos, stock photograph, stock photographs, picture, pictures, graphic, graphics, fine art prints, print, poster, posters, mural, wall murals, gwl10000328
Show Keywords
























